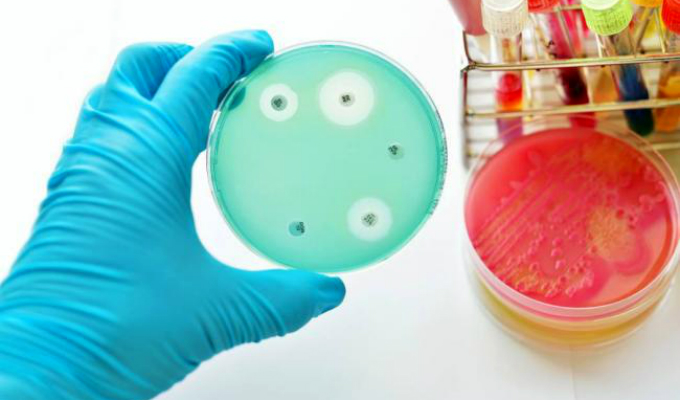

Noticias De "bacteria"

.Estas son las últimas Noticias De bacteria. Para más información relevante sobre Noticias De bacteria, y sobre todo el acontecer nacional e internacional sigue nuestros noticieros mediante nuestra señal en vivo a través de TV EN VIVO GRATIS (Panamericana.pe)
Desde cualquier punto del Perú y/o América Latina, a través de tu PC, tablet o teléfono móvil, podrás ver nuestros noticieros: 24 Horas, Buenos Días Perú y Panorama, así como los programas de entretenimiento y cultura, incluyendo novelas, películas, documentales y las mejores producciones internacionales.
Panamericana TV es la primera cadena televisiva latina en transmitir Televisión en vivo gratis, desde su portal web.
Panamericana Televisión, la televisión que quieres ver.
Desde cualquier punto del Perú y/o América Latina, a través de tu PC, tablet o teléfono móvil, podrás ver nuestros noticieros: 24 Horas, Buenos Días Perú y Panorama, así como los programas de entretenimiento y cultura, incluyendo novelas, películas, documentales y las mejores producciones internacionales.
Panamericana TV es la primera cadena televisiva latina en transmitir Televisión en vivo gratis, desde su portal web.
Panamericana Televisión, la televisión que quieres ver.

Salud • Hace 8 meses
Ralstonia pickettii: lo que se sabe de la bacteria que contaminó un sedante usado en pacientes de UCI

Locales • Hace 8 meses
Minsa descarta que muertos en hospitales tengan relación con uso de sedante contaminado Edetoxin

Locales • Hace 8 meses
Alerta por sedante Edetoxin: Minsa inmoviliza lote por brote de bacteria que afectó a 28 pacientes

Salud • Hace 10 meses
Instituto Nacional de Salud del Niño confirma 12 menores infectados por bacteria Ralstonia Pickettii

Locales • Hace 10 meses
Instituto Nacional del Niño de San Borja: reportan 12 niños afectados y tres fallecidos por bacteria

Salud • Hace un año
¿Sábanas y almohadas sucias? La ciencia revela cada cuanto tiempo se deben lavar para evitar enfermedades

Internacionales • Sábado, 12 de abril del 2025
Al menos 50 hipopótamos murieron en una reserva de África: una bacteria sería la responsable

Internacionales • Domingo, 08 de diciembre del 2024
México: lo que se sabe de los 13 niños que murieron presuntamente por una solución nutricional contaminada

Internacionales • Miércoles, 20 de marzo del 2024
¡Alerta Sanitaria! se incrementa casos de peligrosa infección bacteriana en Japón

Salud • Miércoles, 21 de febrero del 2024
Por qué comer restos de arroz podrían enfermarte: Esto dicen los especialistas

Internacionales • Viernes, 03 de marzo del 2023
Hombre se lava el rostro con agua del caño y fallece por extraña bacteria “comecerebros”

Salud • Viernes, 20 de enero del 2023
Realizan 3500 exámenes y detectan en 44% de casos bacteria causante de enfermedades relacionadas al cáncer gástrico

Salud • Jueves, 22 de setiembre del 2022
25 de setiembre: Día Latinoamericano de la Lucha contra la Pertussis

Internacionales • Martes, 22 de setiembre del 2020
Hallan al causante de la muerte de más de 300 elefantes en Botsuana

Locales • Sábado, 18 de julio del 2020
Indecopi inició proceso sancionador a Clorox por bacteria en Poett

Locales • Martes, 14 de julio del 2020
Bacteria hallada en conocido limpiador podría ser letal en personas con bajas defensas

Locales • Martes, 11 de febrero del 2020
Susalud se pronuncia por casos de niños portadores de bacteria en hospital Cayetano Heredia

Internacionales • Miércoles, 27 de noviembre del 2019
Israel: modifican a bacteria para que se alimente de CO2

Locales • Martes, 22 de octubre del 2019
Síndrome antifosfolípido, la enfermedad que habría provocado el deceso del ex ‘chico reality’
Internacionales • Martes, 11 de setiembre del 2018
Argentina: alerta epidemiológica por bacteria que mató a cuatro niños

Internacionales • Martes, 23 de agosto del 2016
EEUU: alerta por aparición de bacteria come carne

Salud • Miércoles, 04 de mayo del 2016
La enfermedad de Lyme, un mal del que se habla poco pero que afecta a miles de personas

Locales • Miércoles, 04 de mayo del 2016
Denuncian que mujer habría contraído bacteria letal en conocida clínica

Nacionales • Sábado, 18 de abril del 2015



